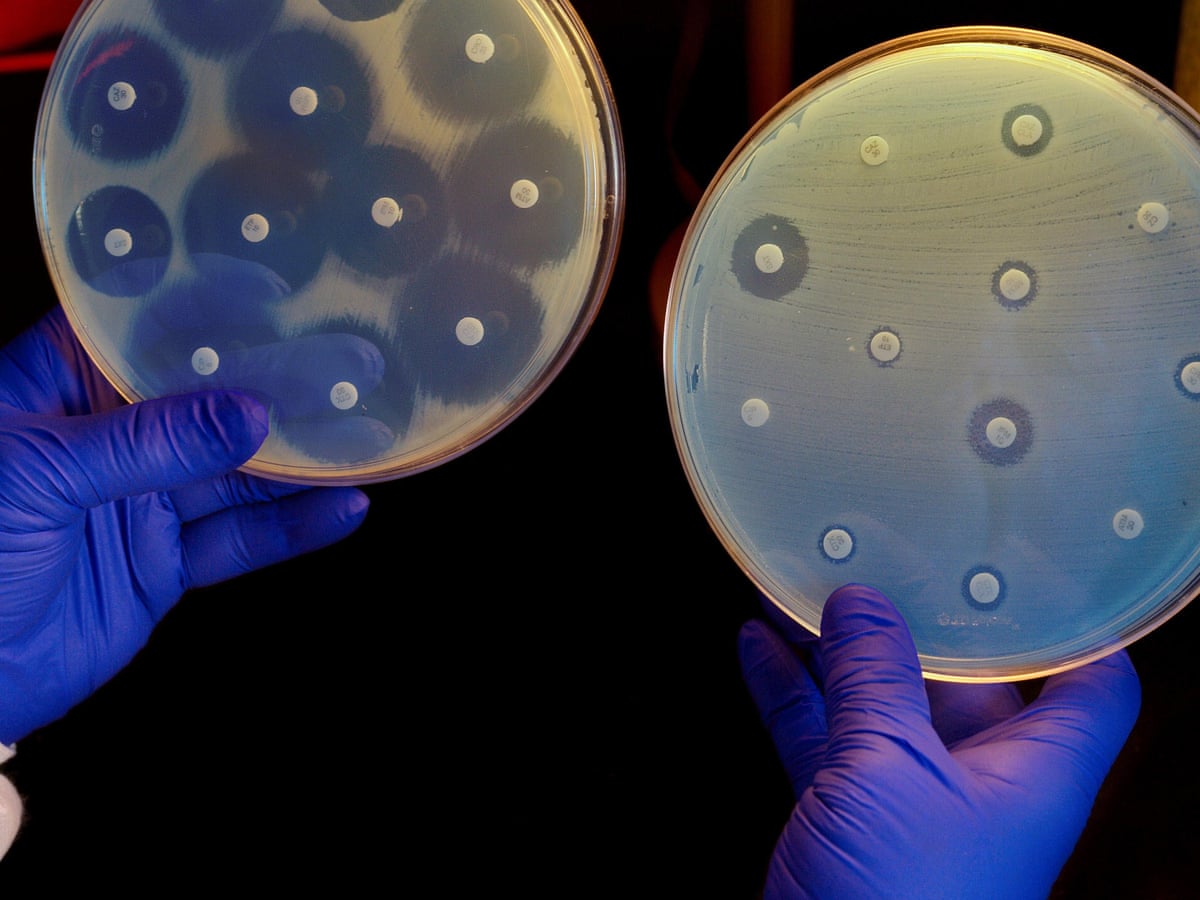
Yapay zekada son gelişme: Bilim insanları, süper bakteriye karşı yeni antibiyotik geliştirdi

Yapay zekada son gelişme: Bilim insanları, süper bakteriye karşı yeni antibiyotik geliştirdi
ABD'li araştırmacılar, “acinetobacter baumannii” ismiyle bilinen süper bakterinin tedavisinde etkili şekilde kullanılacak antibiyotiğin keşfinde yapay zekadan yararlandı.
ABD'li araştırmacılar, “acinetobacter baumannii” ismiyle bilinen süper bakterinin tedavisinde etkili şekilde kullanılacak antibiyotiğin keşfinde yapay zekadan yararlandı.
The Guardian’ın haberine göre, McMaster Üniversitesi ve Massachusetts Institute of Technology (MIT) bünyesindeki bilim insanları, yaptıkları açıklamada, ölümcül süper bakteriyle mücadele edebilecek antibiyotik (abaucin) geliştirildiğini duyurdu.
Araştırmacılar, ilacın geliştirilmesinde binlerce antibakteriyel molekülün yapısını taramaya yarayan yapay zekadan faydalanıldığını kaydetti.
Bilim insanları, yeni modeli kullanarak moleküllere dair yaptıkları inceleme sonucu daha önce hiç karşılaşmadıkları 6 bin 680 bileşeni analiz ettiklerini bildirdi.
Analizler sonrası bu bileşenlerden 240'ını detaylıca inceleyen bilim insanları, 8 yeni potansiyel antibiyotik ile “abaucin”i oluşturan yeni bir antibakteriyel molekülü tespit ettiklerini duyurdu.
Bu yeni molekülü süper bakteri enjekte edilmiş farelerin üzerinde deneyen araştırmacılar, enfeksiyonu baskıladığını keşfetti.
Araştırmacı Gary Liu, kimyasalların bakterilerin üzerindeki etkisini ele alan halihazırdaki verileri yapay zekanın yardımıyla geliştirerek moleküllerin antibakteriyel yapıda olup olmadığını anlamaya yarayan yeni bir model ortaya çıkardıklarını açıkladı.
Liu, yeni yapay zeka modeliyle ilaçların keşfinin daha etkili şekilde yürütülebileceğini ifade etti.
McMaster Üniversitesi'nde Biyokimya ve Biyotıp Bilimleri Bölümünde öğretim üyesi Jonathan Stokes da söz konusu modelin, antibiyotik keşiflerinde yapay zeka kullanımının önemini kanıtladığını kaydetti.

Yapay zeka yardımıyla kimyasal alandaki yeni buluşların ve antibakteriyel molekül keşiflerinin hızlanacağını anlatan Strokes, yapay zekanın bakterilerin direnç kazanma ve evrim geçirme özelliğine karşı kullanılacak antibiyotiklerin bulunmasında önemli rol oynayacağını vurguladı.
Dünya Sağlık Örgütü (DSÖ), yaptığı açıklamada, “acinetobacter baumannii”nin antibiyotiğe dirençli doğasından dolayı insan sağlığına büyük tehdit oluşturduğunu bildirmişti.
Açıklamada, bakterinin yeni tedavilere ivedilikle direnç geliştirme özelliğine sahip olduğu ve bu özelliğini genler yoluyla diğer bakterilere aktarıp onları da ilaçlara karşı dirençli hale getirdiği belirtilmişti.
Uzun süre hayatta kalan süper bakteriler, kanda enfeksiyona ve idrar yolu enfeksiyonlarına sebep oldukları için hastaneler, bakımevleri ve havalandırma aygıtları gibi tıbbi ekipmanları kullanan hastalar için tehdit oluşturuyordu.
Çalışmanın ayrıntıları, “Nature Chemical Biology” dergisinde yayımlandı.
Türkiye yerli hava yollarının uçuş trafiği katlanarak yükseliyor
Eşini katleden sanık, ağırlaştırılmış müebbet hapis cezasına çarptırıldı!
Uçağın kapısı havada açıldı, 194 yolcu korku dolu anlar yaşadı!
Doğalgaz hattı çalışmalarında, tarihi eser kalıntıları bulundu
Türkiye'ye ziyaretçi akını: 4 ayda 11 milyondan fazla ziyaretçiyi ağırladık
Altın alacaklar dikkat! uzmanından tavsiye: “Müşterilerimiz 28 Mayıs sonrasını bekleyebilirler”
Motosiklet satışları patladı! Sıfır araçtaki fiyat artışı motosiklet sektörünü sevindirdi
Elon Musk'ın beyin çipi projesinin insan deneyleri için onay aldığı bildirildi
Arzu Ar davasında karar çıktı, sanık Metin Ar müebbet hapis cezasına çarptırıldı!
ATM’de sıra bekleyen kadınlar yumruklu kavgaya tutuştu
Kılıçdaroğlu'na büyük şok CHP eski kadın kolları başkanı 2. tur seçimlerinde Erdoğan'ı destekleyeceğini açıkladı
Nevşehir’de işyerinde çıkan yangında 1 kişi yaralandı, 3 araçta hasar oluştu
Manisa'da Togg izdihamı yaşandı, vatandaşlar Togg'u meşale ve konfetilerle karşıladı
Kaynak:AA